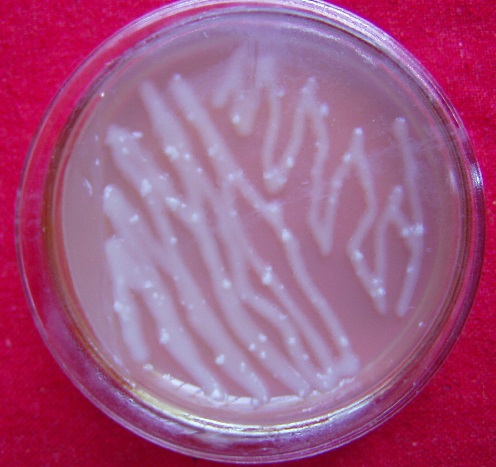
植物转基因有什么是转不出来的,转基因植物的内标准基因有哪些

含苞待放的植物
可以说,大家几乎每天都会听到或见到转基因这几个字,甚至很多人对转基因会有相当大的排斥情绪。谁也不知道所吃的、用的、穿的这些产品是否是转基因产品,因为你无法检测,但这一点无需太担心,国家对转基因产品的管理还是非常严格的,不会随意让它们进入市场。
一、到底什么是转基因植物

DNA与染色体
首先了解一下什么是基因?基因是由一个一个的脱氧核糖核苷酸按一定顺序连接起来的一段物质,它通过一系列的过程,能最终控制某个性状的形成,比如开什么颜色的花,含蛋白质多少等等。

基因控制的颜色
如果我们把这样的一个基因从某个植物里弄出来,通过某种方法让它转到某个植物细胞,然后让这个细胞再长成一个新的植物,发现这个新植物能表现出转进去的这个基因控制的性状,那它就是转基因植物了。
二、基因到底怎么转到细胞里去的?

基因枪
现在的转基因植物常用两种方法来实现的,一种是基因枪法,另一种就是农杆菌介导法。
基因枪有点像平时打气枪,先将基因接到一个脱氧核糖核酸序列上,并构建成一个环状分子,再包在一个肉眼见不到的许多颗粒里面,相当于气枪的*弹铅**,只是基因枪采用的是高压的氮气,不是空气,通过高压气体的作用下,将包裹基因打入细胞中间,所以在细胞中有可能出现三种新情况,有些是打入一个颗粒,有些可能打入多个颗粒,有些没有颗粒进入。
农杆菌
农杆菌介导法也需要先将基因构建成一个环状分子,然后把这个分子用别的方法弄到一个称为农杆菌的细菌里,而这个细菌具有一个特点,它可以自己钻到细胞里面去,也就把基因一起带入细胞了。
三、怎样知道基因进入了细胞?到了细胞后,又会出现哪些结果?

水稻抗性愈伤组织筛选
当然,想要知道基因是否进入了细胞,进行筛选是必不可少的。现在一般采用的都是进行抗性筛选,在前面构建的环状分子上会加入抗生素抗性基因或抗除草剂基因等,如果基因转进去了,这个细胞就会对抗生素或除草剂产生抵抗力,当把它放在这种抗生素或除草剂上时,它就能生存下来,否则就会死掉。存活下来的细胞就是我们所要的了。
当基因进入细胞后,有可能出现几种结果:一种是被细胞当作异物,然后通过某种方法把它清理出细胞;一种是游离在细胞中,随着细胞的分裂,而传递给下一代的细胞;当然,也可能在传递几次后,又会被清除掉;一种就是进入细胞核中间,整合到含有基因的DNA分子上,从而可以不断的传递给下一代了。这就是我们通常所说的转基因细胞了。
四、转基因植物又是怎样形成的?

植物组织培养
通过前面的筛选,大家获得了转基因的细胞,这些植物细胞具有一个非常好的特征,当在某种适当的条件下,经过一段时间后可以重新长成一个个的小植物,如果这些植物正好是转基因细胞长成的,那就是转基因植物了。
当然,要想从一个细胞长成一个小植物,需要一种新技术的参与了,就是大家平时熟知的植物组织培养技术。关于这个技术,我们将在以后的科普中给大家作详细介绍。
然而,转基因植物确实可能获得了非常好的一些特征,但现在让人们一下子全部接受它,还存在很大困难的,毕竟这个新植物产品确实也存在相当大的风险,这也是为什么全世界各国对转基因产品要进行严格管理的原因了。下次将重点给大家讨论转基因的风险到底在哪里。
欢迎关注@探秘生物